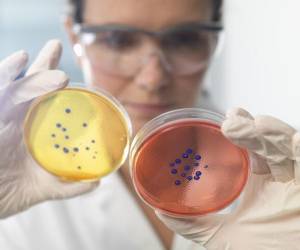

میکروب و عفونت بدن در کدام عضو بدن بیشتر است؟
برخلاف تصور بسیاری از ما میکروب ها و باکتری ها، قارچ ها و ویروس های زیادی در بدن ما زندگی می کنند و ما همواره یک اکوسیستم غنی از میکروب ها را جابه جا می کنیم . آیا می دانید میکروب و عفونت بدن در کدام عضو بدن بیشتر است؟ این بخش از سلامت نمناک را مطالعه بفرمایید تا پاسخ این سوال خود را دریابید.
پر میکروب ترین و عفونی ترین عضو بدن انسان کجاست؟
محل زندگی میکروب و عفونت بدن
تحقیقات جدید نشان داده است که مجموعه ای از میکروب ها شامل باکتری ها، قارچ ها و ویروس ها در روده، دهان و حتی هوای اطراف ما زندگی می کنند و ما آنها را هر روزه همراه خود جابه جا می کنیم.
اخیرا یک مطالعه جدید این نکته را مورد اشاره قرار داده است که برخی از این اشکال ناشناخته ممکن است به ما بسیار نزدیکتر از آنچه تصور می شود باشند؛ جایی در داخل روده انسان.
میکروب هایی که در روده ما زندگی می کنند از بهترین نمونه های مطالعه شده در جهان علم هستند که با استفاده از آن می توان ماده تاریک حیات را کشف نمود. با استفاده از آنالیز DNAمی توان گونه های جدید را براساس ژنوم منحصر به فردشان شناسایی کرد اما در مورد باکتری ها مسأله دشوارتر است و انتقال ژن ها شناسایی، تشخیص و ردیابی گونه های باکتری را با مشکل روبرو کرده است زیرا باکتری ها بخش هایی از DNA خود را با یکدیگر به اشتراک می گذارند .
محققان برای غلبه به این مشکل ، تحقیقات خود را بر روی آن دسته از ژن هایی که معمولا در بین میکروب ها منتقل نمی شوند، آغاز نمودند .
بیشترین عفونت و میکروب در روده انسان
کشف محل رشد میکروب و عفونت بدن
آنها حدودا 230 هزار پروتئین از DNA را کشف نمودند که به 86 خانواده ژنی ارتباط داشت . در تحقیقات بعدی محققان 80 هزار توالی دیگر از DNA را کشف کردند که به همان 86 خانواده مرتبط بود. حدود یک سوم از پروتئین های DNA تنها در 60 درصد از بازها و توالی های خود مشترک هستند. این تفاوت بین باکتری ها و آرک ها یی یافت می شود که هر کدام متعلق به یک قلمرو از موجودات زنده دارند.
سه قلمرو از موجودات زنده مانند یوکاریوت ها (شامل حیوانات، گیاهان و قارچ ها )، باکتری ها و آرک ها وجود دارد . به عنوان چهارمین دامنه یا قلمرو موجودات زنده می توان باکتری ها با این میزان تفاوت در توالی های ژنی را در نظر گرفت.
کشف محل زندگی میکروب و عفونت در روده
منشا تنوع و تفاوت بین باکتری ها و آرک ها می تواند تفاوت های خیلی زیاد بین توالی های DNA باشد . محققان در مرحله بعدی تحقیقات خود در نظر دارند که برخی از موجودات زنده که حاوی این توالی های غیر معمول هستند را شناسایی کنند و بعد توالی ژنوم آنها را تعیین نمایند.




 عوارض آمپی سیلین برای همه بخصوص زنان باردار
عوارض آمپی سیلین برای همه بخصوص زنان باردار ملین خانگی برای پاکسازی کامل روده ها
ملین خانگی برای پاکسازی کامل روده ها روش پاکسازی روده و دستگاه گوارش با آب نمک
روش پاکسازی روده و دستگاه گوارش با آب نمک بوعلی سینا انسداد روده را چطور درمان میکرد؟
بوعلی سینا انسداد روده را چطور درمان میکرد؟ 6 باید مهم تغذیه فردی که روده تحریک پذیر دارد
6 باید مهم تغذیه فردی که روده تحریک پذیر دارد روده ناسالم حتما این علائم را دارد
روده ناسالم حتما این علائم را دارد شیگلوز ؛ بیماری که کوچک و بزرگ نمی شناسد
شیگلوز ؛ بیماری که کوچک و بزرگ نمی شناسد راه رسیدن به روده ی سالم از اینجاست
راه رسیدن به روده ی سالم از اینجاست